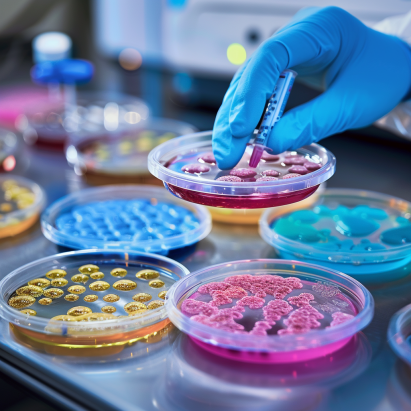

Parasitología y urinálsis de la calidad que se merece
En nuestro laboratorio clínico de vanguardia, ofrecemos servicios de parasitología y urinálisis con tecnología de última generación. Nuestro equipo experimentado garantiza resultados precisos y confiables para tu tranquilidad y salud. Descubre la excelencia en atención médica y diagnósticos precisos con nosotros.
¿Cuándo es necesario realizar exámenes de parasitología?
Siempre es bueno revisar nuestra salud aunque no presentemos síntomas... Mejor prevenir que curar. Pero veamos algunos síntomas muy comúnes a continuación (no es una lista completa de todos los síntomas existentes pero si de los más comúnes).
Diarrea persistente: La diarrea que dura más de una semana puede ser un signo de infección parasitaria gastrointestinal, especialmente si está acompañada de otros síntomas como cólicos abdominales y heces con sangre o moco. | Heces anormales: Cambios en la frecuencia, consistencia o apariencia de las heces, como diarrea con sangre, heces con aspecto aceitoso o presencia de parásitos visibles en las heces, pueden indicar una infección parasitaria. |
Pérdida de peso inexplicable: La presencia de parásitos en el tracto gastrointestinal puede interferir con la absorción de nutrientes, lo que puede llevar a una pérdida de peso no deseada a pesar de tener un apetito normal o incluso aumentado. | Fatiga crónica: Las infecciones parasitarias pueden causar fatiga persistente y debilitante, incluso después de descansar adecuadamente, debido a la interferencia con la absorción de nutrientes y a la respuesta del sistema inmunológico del cuerpo. |
Picazón anal: La presencia de ciertos parásitos intestinales, como los oxiuros, puede provocar picazón intensa en la zona anal, especialmente por la noche. | Náuseas y vómitos: Los parásitos intestinales pueden causar molestias estomacales, incluyendo náuseas y vómitos recurrentes, especialmente después de comer. |
Malestar abdominal: Dolores abdominales recurrentes, hinchazón, gases y cólicos pueden ser síntomas de una infección parasitaria en el tracto gastrointestinal. | Erupciones cutáneas: Algunas infecciones parasitarias, como la larva migrans cutánea, pueden causar erupciones cutáneas pruriginosas y enrojecidas en la piel, especialmente en áreas expuestas al suelo contaminado. |
Si usted o algún ser querido se encuentra experimentando alguno de estos síntomas o tienes/tiene preocupaciones sobre tu/su salud relacionadas con los parasitos, es importante consultar para recibir una evaluación completa y un diagnóstico preciso. De tal forma que evites un problema de salud en el corto, mediano y largo plazo.
Servicio de urinálisis y parasitología de calidad
¿Cuáles son los exámenes parasitológicos más solicitados?
Cultivo de semen
Este examen consiste en cultivar una muestra de orina para detectar la presencia de parásitos u organismos patógenos en el tracto urinario. Puede ser utilizado para diagnosticar infecciones parasitarias como la esquistosomiasis o la infección por Trichomonas.
Cultivo de faríngeo
En este examen se toma una muestra de la garganta del paciente para cultivar y detectar la presencia de parásitos o microorganismos patógenos que puedan causar infecciones en la garganta, como la amebiasis o la infección por Giardia.
Cultivo de semen
Es un examen en el que se analiza una muestra de semen en busca de la presencia de parásitos u organismos infecciosos, como por ejemplo, Trichomonas vaginalis, que puede causar infecciones genitales.
Cultivo de secreción
Se toma una muestra de la secreción (por ejemplo, vaginal, anal o de cualquier otra área) para identificar la presencia de parásitos o microorganismos que puedan estar causando una infección en esa área específica del cuerpo. Este examen puede ser utilizado para diagnosticar infecciones por Trichomonas, Candida u otras infecciones parasitarias o fúngicas.
Cultivo de heces (coprocultivo)
Se realiza con el fin de detectar la presencia de parásitos intestinales o sus huevos en las heces del paciente. Este examen es fundamental en el diagnóstico de infecciones parasitarias como la amebiasis, la giardiasis, la teniasis, entre otras.
Hay muchos otros exámenes que se pueden realizar en nuestro laboratorio clínico. Si presentas algún síntoma, mientras antes te realizes un exámen clínico será mucho mejor para tu salud.
Puedes reservar tu turno dentro de las 24 horas del día.
Nuestro laboratorio clínico te garantiza CALIDAD
Obtenga resultados precisos y confiables en sus exámenes de parasitología con nuestro laboratorio clínico dónde estudiamos las características morfológicas de parásitos y las especies de parásitos de importancia médica. Nuestros profesionales altamente capacitados y con años de experiencia garantizan la calidad de sus resultados. Equipados con tecnología moderna y de última generación, nuestro laboratorio ofrece la máxima precisión y fiabilidad en cada análisis.
Confíe en nosotros para obtener resultados de calidad que le brinden tranquilidad y confianza en su salud.
¿Cómo se hace un uroanálisis?
El uroanálisis, también conocido como análisis de orina, es un procedimiento médico estándar que proporciona información valiosa sobre la salud del paciente. A continuación te presentamos los pasos que respetamos en nuestro laboratorio para realizar un uroanálisis:
- Recolecta de la muestra: Se facilita un recipiente estéril al paciente para que recolecte una muestra sin contaminación de orina limpia. Es importante seguir las instrucciones para evitar errores en la muestra.
- Etiquetado y registro: Una vez recolectada la muestra, se etiqueta adecuadamente con la información del paciente y se registra en el laboratorio para su seguimiento.
- Exámen médico visual: Se realiza una inspección visual de la muestra para evaluar su color, transparencia y la existencia posible de cualquier otra anomalía, como presencia de sangre o pus.
- Análisis físico: Se realizan pruebas físicas para medir parámetros como pH, densidad y concentración de la orina, utilizando tiras reactivas especiales.
- Examen médico microscópico: Se analiza la muestra bajo el microscopio para detectar la presencia de células sanguíneas, bacterias, cristales u otros elementos anormales.
- Cultivo bacteriano (si es necesario): En caso de sospecha de infección del tracto urinario, se puede realizar un cultivo bacteriano para identificar el tipo específico de bacteria y determinar el tratamiento adecuado.
- Interpretación de los resultados: Los resultados del uroanálisis se interpretan en conjunto con la historia clínica del paciente y otros hallazgos médicos para llegar a un diagnóstico preciso y planificar el tratamiento adecuado.